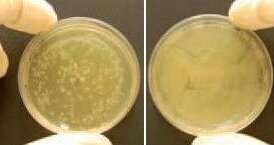
Prozone potwierdza skuteczność ozonu w leczeniu stomatologicznym

Kontrola płytki stanowi podstawę profilaktyki i kontroli chorób przyzębia oraz próchnicy. Mimo że przepływ śliny powoduje w ograniczonym zakresie usuwanie resztek z przestrzeni międzyzębowych i zagłębień na powierzchniach zwarciowych, to jest mniej skuteczny w zakresie usuwania płytki.
Naturalne oczyszczanie zębów przez siły fizjologiczne, tzn. ruchy języka i policzków, praktycznie nie występuje. Z tego względu kontrola płytki wymaga jej usuwania przy użyciu aktywnych metod. Wyniki dużych badań kohortowych wykazały, że wysoki poziom higieny jamy ustnej zapewnia skuteczne usuwanie płytki nazębnej. Istnieją poważne dowody na to, że szczotkowanie zębów pozwala kontrolować płytkę, pod warunkiem jednak, że jest przeprowadzane dostatecznie dokładnie i z właściwą częstotliwością. Do czynników, które wpływają na skuteczność szczotkowania zębów należą: budowa szczoteczki, sposób jej działania, łatwość użycia oraz współpraca pacjenta.
Przeglądy systematyczne
Stomatologia oparta na wynikach badań (Evidence Based Dentistry) oznacza takie podejście do pielęgnacji zdrowia jamy ustnej, które wymaga rozsądnej integracji systematycznych przeglądów wyników badań klinicznych o znaczeniu praktycznym z doświadczeniem klinicznym pracownika gabinetu stomatologicznego, potrzebami leczniczymi i preferencjami pacjenta oraz dostępnymi narzędziami. Obecnie uważa się, że systematyczne prace przeglądowe zapewniają najwyższy poziom dowodów i stanowią główne narzędzie służące podsumowaniu istniejących wyników badań w powtarzalny, systematyczny sposób. Są wobec tego kluczowe dla podejmowania decyzji na podstawie wyników badań.
Systematyczne przeglądy różnią się od tradycyjnych prac poglądowych tym, że zwykle są ograniczone do jednego tylko pytania, w oparciu o które przeprowadza się systematyczne wyszukiwanie, wybór i ocenę kliniczną istotnych badań. Systematyczne przeglądy minimalizują ryzyko błędu systematycznego oraz pozwalają uzyskać wszechstronny współczesny stan wiedzy na dany temat. Analizy tego typu są obiektywne w ocenie i przejrzyste w analizie zmienności, dzięki czemu pozwalają innym na samodzielną ocenę metodologii i jakości samej pracy przeglądowej. Przeprowadzając metaanalizę dostatecznie zbliżonych do siebie badań można obliczyć sumaryczne szacowane wartości wspólnej średniej, co prowadzi do zmniejszenia zmienności wyników oraz zwiększenia ich znaczenia. Cochrane Handbook for Systematic Reviews of Interventions podaje, że analizy przeglądowe są niezbędne dla zapewnienia, że decyzje zdrowotne są podejmowane w oparciu o zawierające istotną treść współczesne wyniki badań wysokiej jakości. Ponadto American Dental Association donosi o uruchomieniu internetowej bazy Center for Evidence-Based Dentistry, która zawiera ponad 1600 klinicznie istotnych, systematycznych badań przeglądowych.
Zasada PICO(S)
Protokół systematycznego badania przeglądowego zaczyna się od starannie sformułowanego pytania, opartego o zasadę PICO(S) – pacjent (Patient), interwencja (Intervention), porównanie (Comparison), parametry oceny końcowej (Outcome parameters) i projekt badania (Study design). Sposób sformułowania pytania ma decydujące znaczenie dla interpretacji wyników badania. Po spisaniu protokołu badania przeprowadza się obiektywną analizę piśmiennictwa w celu znalezienia odpowiednich artykułów przy jak najmniejszym ryzyku przeoczenia jakiegokolwiek badania. Parametry użyte do oceny wyników również mają istotne znaczenie dla wniosków. Przykładem takiego parametru jest redukcja płytki i zapalenia dziąseł w związku ze stosowaniem różnego rodzaju szczoteczek do zębów.
Szczotkowanie zębów
Już starożytni Egipcjanie wykorzystywali mechaniczne narzędzia do rutynowego oczyszczania zębów. Wykonywali szczoteczki, żując jeden koniec gałązki tak, aby ją wystrzępić. Dzisiaj istnieją setki szczoteczek ręcznych o różnym kształcie, w tym szczoteczki o takiej budowie włosia, które ma ułatwiać usuwanie płytki z trudnodostępnych obszarów, szczególnie z przestrzeni interproksymalnych. Duży nacisk kładzie się także na nowe rozwiązania ergonomiczne, np. wielkość uchwytu szczoteczki dostosowaną do wielkości dłoni użytkownika, jednak nawet dorośli, pomimo widocznych wysiłków nie są w stanie usunąć płytki tak skutecznie, jak można by tego oczekiwać.
Skuteczność ręcznych szczoteczek do zębów w systematycznej pracy przeglądowej
Badania ćwiczeń szczotkowania zębów, stosowane powszechnie do oceny szczoteczek, stanowią przydatny wskaźnik zdolności szczoteczki do usuwania płytki oraz ułatwiają kontrolę takich czynników zakłócających, jak współpraca pacjenta. W przeprowadzonym ostatnio systematycznym badaniu przeglądowym oceniano skuteczność ręcznych szczoteczek do zębów w zależności od ich kształtu i czasu szczotkowania po takich ćwiczeniach. Analiza piśmiennictwa przyniosła 2079 tytułów i abstraktów, spośród których kryteria kwalifikacji spełniało 59 badań z 212 ćwiczeniami szczotkowania jako oddzielnymi etapami badań oraz 10 806 uczestnikami. Na podstawie średniej wartości wskaźnika płytki przed i po szczotkowaniu obliczono ogólną średnią ważoną redukcję wskaźnika płytki (42%).
Szczególna wartość wyników wynikała z dużej liczby uczestników i zmienności obserwowanej w projektach poszczególnych badań, ponieważ odzwierciedlają one sytuacje, jakich można oczekiwać w zakresie higieny jamy ustnej od ogólnej populacji. W przeprowadzonych badaniach stwierdzono średnią ważoną redukcję wskaźnika płytki wg Quigleya-Heina o 30% (95% CI: 27-33%), natomiast w przypadku badań wykorzystujących wskaźnik płytki wg Navy, jego średnia ważona redukcja wynosiła 53% (95% CI: 50-56%). Analiza w podgrupach w zależności od układu pęczków włosia wykazała różną zdolność usuwania płytki (24-61%). Najwyższą ogólną średnią ważoną redukcję wskaźnika płytki (niezależnie od użytego wskaźnika) zapewniało włosie ustawione pod kątem. Analiza wpływu czasu trwania szczotkowania wykazała ogólną średnią ważoną redukcję wskaźnika płytki o 27% po 1 min. szczotkowania oraz o 41% po 2 min. minutach. Na tej podstawie wywnioskowano, że skuteczne usuwanie płytki prowadziło do ogólnej średniej ważonej redukcji wskaźnika płytki o 42% (30-53% w zależności od wybranego wskaźnika płytki). Dostępne dane wskazują, że ustawienie pęczków włosia (płasko przycięte, wielopoziomowe, ustawione skosem) oraz czas trwania szczotkowania to zmienne związane ze skutecznością usuwania płytki. Niezależnie od zastosowanego wskaźnika wydaje się, że można jeszcze poprawić jakość szczotkowania z użyciem szczoteczek ręcznych.
Szczoteczki elektryczne
Pierwszą skuteczną szczoteczkę elektryczną (Broxodent) opracował w 1954 r. w Szwajcarii dr Philippe-Guy Woog. Pierwsza generacja szczoteczek elektrycznych miała główkę o kształcie analogicznym do szczoteczek ręcznych i wykonywała połączone ruchy poziome i pionowe. W latach 80. XX w. rozpoczął się szybki postęp w tej dziedzinie. Od tego czasu stworzono różne szczoteczki elektryczne w celu poprawy skuteczności usuwania płytki.
Dostępne na rynku szczoteczki elektryczne różnią się pod względem działania. Szczoteczki oscylacyjno-rotacyjne mają okrągłą główkę, która porusza się na przemian w kierunku zgodnym i przeciwnym do ruchu wskazówek zegara. Szczoteczki o ruchu okrężnym obracają się tylko w jednym kierunku, szczoteczki kontroscylacyjne mają pęczki włókien, które obracają się tam i z powrotem niezależnie od pozostałych włókien, inne (w tym szczoteczki soniczne) wykonują ruchy przód-tył. W kolejnych latach prowadzone były pojedyncze badania dotyczące skuteczności i bezpieczeństwa poszczególnych kategorii szczoteczek elektrycznych, a łącznie wyniki opisano w systematycznych pracach przeglądowych.
Szczoteczki elektryczne vs szczoteczki ręczne
Jedna z pierwszych stomatologicznych systematycznych prac przeglądowych powstała we współpracy z Cochrane Oral Health Group i dotyczyła porównania szczoteczek elektrycznych i ręcznych w codziennym użyciu, a w szczególności pod względem usuwania płytki nazębnej i zdrowia dziąseł. W ramach tej pracy przeszukano 5 elektronicznych baz danych, poszukując randomizowanych badań z grupą kontrolną, porównujących szczoteczki elektryczne i ręczne (do połowy 2002 r.), w których uczestnikami były osoby z populacji ogólnej, w pełni sprawne fizycznie, które szczotkowały zęby bez nadzoru przez co najmniej 4 tygodnie. Pierwszą aktualizację tej pracy wykonali Robinson i wsp. (2005), ostatnią opublikowali Yacoob i wsp. (2011). Łącznie w pracy przeglądowej uwzględniono 50 spełniających kryteria badań, obejmujących 4326 uczestników i wolnych od stwierdzonego błędu systematycznego dotyczącego publikacji.
Oscylacyjno-rotacyjne szczoteczki elektryczne zapewniały większą redukcję płytki oraz zapalenia dziąseł w porównaniu do szczoteczek ręcznych. Standaryzowana średnia różnic dla redukcji płytki i zapalenia dziąseł w krótkotrwałej obserwacji (1-3 miesięcy) wynosiła odpowiednio 0,53 (95% CI: -0,74 do -0,31) oraz 0,49 (95% CI: -0,73 do -0,26). Także w perspektywie długoterminowej (powyżej 3 miesięcy) stwierdzono znamiennie większą redukcję płytki i zapalenia dziąseł, m.in. o ok. 27% mniej miejsc wykazujących krwawienie przy zgłębnikowaniu.
Na podstawie tej ostatniej pracy przeglądowej stwierdzono, że wyłącznie w odniesieniu do szczoteczek oscylacyjno-rotacyjnych istnieją jednoznaczne dowody na kliniczną ich przewagę nad szczoteczkami ręcznymi oraz większą zdolność redukcji płytki i zapalenia dziąseł. Wyniki te potwierdzają obserwacje i wnioski z wcześniejszych prac przeglądowych, w których porównywano elektryczne i ręczne szczoteczki do zębów.
Porównanie różnych szczoteczek elektrycznych
Najnowsza praca przeglądowa Cochrane poświęcona była ocenie porównawczej skuteczności szczoteczek elektrycznych o różnej budowie oraz ich wpływu na zdrowie jamy ustnej. Przeszukano 5 elektronicznych baz danych w poszukiwaniu prac przeprowadzonych do lipca 2010 r. Znaleziono 17 kwalifikujących się badań, obejmujących razem ponad 1300 uczestników. Kryteriami wyboru badania były: randomizacja, porównanie co najmniej 2 szczoteczek elektrycznych o różnych mechanizmie działania i objęcie badaniem co najmniej 4 tygodni szczotkowania bez nadzoru oraz pełna sprawność manualna uczestników. Oceniano szczoteczki o ruchach oscylacyjno-rotacyjnych, kontroscylacyjnych, przód-tył, okrężnych, ultradźwiękowe, wielowymiarowe oraz jonowe (aktywne elektrycznie).
Na podstawie 7 badań o czasie trwania do 3 miesięcy, bez znaczącego zróżnicowania stwierdzono, że szczoteczki oscylacyjno-rotacyjne powodowały znacząco większą redukcję płytki w obserwacji krótkookresowej (1-3 miesięcy) w porównaniu do szczoteczek o ruchach przód-tył. Standaryzowana średnia różnic wyniosła 0,24 (95% CI: 0,02-0,46). Klinicznie wyższość szczoteczek oscylacyjno-rotacyjnych nad szczoteczkami o ruchach przód-tył wyrażała się 7% redukcją wartości wskaźnika płytki wg Quigley-Hein w modyfikacji Turesky'ego. Standaryzowana średnia różnic, wynosząca 0,35 (95% CI: -0,04 do 0,74), nie była znamienna statystycznie. Ponieważ dostępne było tylko jedno badanie o czasie trwania powyżej 3 miesięcy przeprowadzone na niewielkiej grupie uczestników, nie było możliwe wyciągnięcie długoterminowych wniosków.
Bezpieczeństwo szczoteczek elektrycznych
W ostatnim czasie przeprowadzono systematyczną analizę przeglądową bezpieczeństwa szczoteczek oscylacyjno-rotacyjnych w porównaniu do szczoteczek ręcznych dla tkanek twardych i miękkich. Po przeszukaniu kilku elektronicznych baz danych wybrano 35 oryginalnych prac do uwzględnienia w przeglądzie, które pogrupowano w zależności od typu badania (randomizowane badania z grupą kontrolną, gdzie bezpieczeństwo było głównym parametrem oceny końcowej; badania, w których bezpieczeństwo było drugorzędowym parametrem oceny; badania, które wykorzystywały zastępczy marker bezpieczeństwa oraz badania laboratoryjne).
Autorzy przeglądu podsumowali go słowami: „Niniejsza systematyczna praca przeglądowa, oparta o liczne dane pochodzące z badań opublikowanych w ostatnich 20 latach wykazała jednoznacznie, że szczoteczki oscylacyjno-rotacyjne są bezpieczne w porównaniu do szczoteczek ręcznych i nie stanowią klinicznie istotnego zagrożenia ani dla tkanek twardych, ani miękkich”. Wyniki te są zgodne z obserwacjami, jakie poczynili w swoich pracach przeglądowych Robinson i wsp. (2005) oraz Yacoob i wsp. (2011), co potwierdza bezpieczeństwo elektrycznych szczoteczek oscylacyjno-rotacyjnych. Obecnie nie są dostępne systematyczne prace przeglądowe dotyczące bezpieczeństwa innego rodzaju szczoteczek elektrycznych.
Inne czynniki
Stomatologia oparta na faktach ma istotne znaczenie dla podejmowania decyzji. Należy jednak zaznaczyć, że efekt kliniczny może nie być jedynym czynnikiem, od którego ta decyzja zależy, np. szczoteczki elektryczne są łatwiejsze w użyciu i mogą poprawiać współpracę ze strony pacjenta, ale ich wyższy koszt może wpływać na decyzję pacjenta o zakupie. Skuteczność usuwania płytki zależy ostatecznie od tego, jak pacjent szczotkuje zęby. Rolą personelu stomatologicznego jest wspieranie i motywacja pacjenta. Cechy takie jak wbudowany timer i wzrokowe sygnały na obudowie szczoteczki pomagają uzyskać większe zaangażowanie ze strony użytkownika i prowadzą do poprawy jakości szczotkowania i współpracy pacjenta.
Podsumowanie
Na podstawie dostępnych wyników badań wykazano, że szczoteczki oscylacyjno-rotacyjne prowadzą do większej redukcji płytki i zapalenia dziąseł w porównaniu do szczoteczek ręcznych. Ponadto w badaniach krótkoterminowych szczoteczki oscylacyjno-rotacyjne wypadły lepiej niż szczoteczki wykonujące ruchy przód-tył. Dla szczoteczek elektrycznych o innych typach ruchów nie są dostępne dostateczne dane. Systematyczne badania przeglądowe dowodzą także bezpieczeństwa szczoteczek oscylacyjno-rotacyjnych.
Piśmiennictwo dostępne u wydawcy.
Kontakt:
Fridus Van der Weijden lub Dagmar Else Slot
Department of Periodontology
Academic Centre for Dentistry Amsterdam
University of Amsterdam and VU University Amsterdam
Gutav Mahlerlaan 3004
1080 LA Amsterdam
Holandia
Tel.: +31 20 5980 179/307
E-mail: g.vd.weijden@acta.nl, d.slot@acta.nl
Zdaniem ekspertów, regularne i prawidłowe szczotkowanie zębów to jeden z najprostszych sposobów na zmniejszenie ryzyka rozwoju ...
Jak podaje Światowa Organizacja Zdrowia, niemal 3,5 mld osób (prawie 45% światowej populacji) zmaga się z różnego rodzaju schorzeniami jamy ustnej, w ...
Szczotkowanie zębów jest jednym z najprostszych, najbardziej dostępnych, a zarazem wysoce skutecznych sposobów zapobiegania chorobom jamy ustnej. Wg ...
Nowe badanie zaprezentowane podczas Sesji Naukowych American Heart Association w 2018 r. sugeruje, że szczotkowanie zębów co najmniej 2 razy dziennie ...
SENDAI, Japonia: Naukowcy z Uniwersytetu Tohoku w Japonii odkryli, że zdrowie psychiczne matki może odgrywać znaczącą rolę we wpajaniu dzieciom ...
Naukowcy odkryli, że użycie nici dentystycznej przed szczotkowaniem zębów może być elementem higieny zwiększającym dokładność usuwania płytki ...
Według badań pewne cechy mogą definiować rodzaj obturacyjnego bezdechu sennego (OBS), który można skutecznie leczyć za pomocą specjalnego ...
Kalifornijscy naukowcy pracują nad małym, ale potężnym sojusznikiem, który może pomóc w zapobieganiu infekcjom po leczeniu kanałowym. W badaniu ...
Ze względu na łatwą aplikację, przystępną cenę i niskie ryzyko połknięcia produktu, lakier fluorowy (FV) stał się popularnym lekiem przeciw ...
Badania kliniczne przeprowadzone w Zakładzie Biologii Molekularnej Uniwersytetu w Salzburgu (Austria) potwierdziły, że leczenie stomatologiczne z ...
Webinarium na żywo
czw. 25 czerwca 2026
8:00 (CET) Warsaw
Dr. Hatem Algraffee, Cat Edney
Webinarium na żywo
wto. 30 czerwca 2026
5:00 (CET) Warsaw
Webinarium na żywo
wto. 30 czerwca 2026
7:30 (CET) Warsaw
Prof. Dr. Anahita Jablonski-Momeni
Webinarium na żywo
śro. 1 lipca 2026
2:00 (CET) Warsaw
Linda Hecker MS, BSDH, RDH
Webinarium na żywo
śro. 1 lipca 2026
2:00 (CET) Warsaw
Webinarium na żywo
czw. 2 lipca 2026
5:00 (CET) Warsaw
Dr. Albéric Santamaria-Loisy
Webinarium na żywo
czw. 2 lipca 2026
8:00 (CET) Warsaw



 Austria / Österreich
Austria / Österreich
 Bośnia i Hercegowina / Босна и Херцеговина
Bośnia i Hercegowina / Босна и Херцеговина
 Bułgaria / България
Bułgaria / България
 Chorwacja / Hrvatska
Chorwacja / Hrvatska
 Czechy i Słowacja / Česká republika & Slovensko
Czechy i Słowacja / Česká republika & Slovensko
 Francja / France
Francja / France
 Niemcy / Deutschland
Niemcy / Deutschland
 Grecja / ΕΛΛΑΔΑ
Grecja / ΕΛΛΑΔΑ
 Węgry / Hungary
Węgry / Hungary
 Włochy / Italia
Włochy / Italia
 Holandia / Nederland
Holandia / Nederland
 nordycki / Nordic
nordycki / Nordic
 Polska / Polska
Polska / Polska
 Portugalia / Portugal
Portugalia / Portugal
 Rumunia i Mołdawia / România & Moldova
Rumunia i Mołdawia / România & Moldova
 Słowenia / Slovenija
Słowenia / Slovenija
 Serbia i Czarnogóra / Србија и Црна Гора
Serbia i Czarnogóra / Србија и Црна Гора
 Hiszpania / España
Hiszpania / España
 Szwajcaria / Schweiz
Szwajcaria / Schweiz
 indyk / Türkiye
indyk / Türkiye
 Wielka Brytania i Irlandia / UK & Ireland
Wielka Brytania i Irlandia / UK & Ireland
 Międzynarodowy / International
Międzynarodowy / International
 Brazylia / Brasil
Brazylia / Brasil
 Kanada / Canada
Kanada / Canada
 Ameryka Łacińska / Latinoamérica
Ameryka Łacińska / Latinoamérica
 USA / USA
USA / USA
 Chiny / 中国
Chiny / 中国
 Indie / भारत गणराज्य
Indie / भारत गणराज्य
 Pakistan / Pākistān
Pakistan / Pākistān
 Wietnam / Việt Nam
Wietnam / Việt Nam
 ASEAN / ASEAN
ASEAN / ASEAN
 Izrael / מְדִינַת יִשְׂרָאֵל
Izrael / מְדִינַת יִשְׂרָאֵל
 Algieria, Maroko i Tunezja / الجزائر والمغرب وتونس
Algieria, Maroko i Tunezja / الجزائر والمغرب وتونس
 Bliski Wschód / Middle East
Bliski Wschód / Middle East

To post a reply please login or register